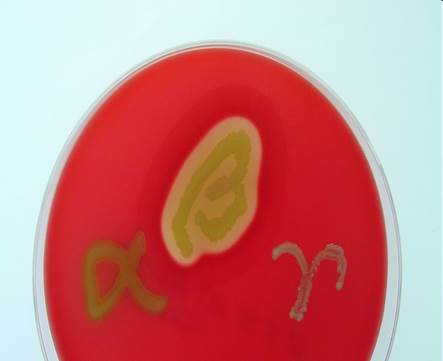

КАТЕГОРИИ:
Архитектура-(3434)Астрономия-(809)Биология-(7483)Биотехнологии-(1457)Военное дело-(14632)Высокие технологии-(1363)География-(913)Геология-(1438)Государство-(451)Демография-(1065)Дом-(47672)Журналистика и СМИ-(912)Изобретательство-(14524)Иностранные языки-(4268)Информатика-(17799)Искусство-(1338)История-(13644)Компьютеры-(11121)Косметика-(55)Кулинария-(373)Культура-(8427)Лингвистика-(374)Литература-(1642)Маркетинг-(23702)Математика-(16968)Машиностроение-(1700)Медицина-(12668)Менеджмент-(24684)Механика-(15423)Науковедение-(506)Образование-(11852)Охрана труда-(3308)Педагогика-(5571)Полиграфия-(1312)Политика-(7869)Право-(5454)Приборостроение-(1369)Программирование-(2801)Производство-(97182)Промышленность-(8706)Психология-(18388)Религия-(3217)Связь-(10668)Сельское хозяйство-(299)Социология-(6455)Спорт-(42831)Строительство-(4793)Торговля-(5050)Транспорт-(2929)Туризм-(1568)Физика-(3942)Философия-(17015)Финансы-(26596)Химия-(22929)Экология-(12095)Экономика-(9961)Электроника-(8441)Электротехника-(4623)Энергетика-(12629)Юриспруденция-(1492)Ядерная техника-(1748)
Справочные материалы 1 страница
|
|
|
|
ТВОРЧЕСКИЕ ЗАДАНИЯ.
ТЕСТОВЫЕ ЗАДАНИЯ ДЛЯ САМОКОНТРОЛЯ
Выберите правильный ответ:
1. gnathalgia
1) боль в челюсти
2) головная боль
3) боль в языке
4) боль при поглаживании волос
2. haematuria
1) наличие мочевины в крови
2) наличие сахара в крови
3) наличие сахара в моче
4) наличие крови в моче
3. encephalomyelitis
1) воспаление головного мозга
2) воспаление мозговой оболочки
3) воспаление головного и спинного мозга
4) воспаление спинного мозга
4. rhinoplastica
1) пластика губы
2) пластика языка
3) пластика носа
4) пластика кости
5. leucopenia
1) процесс образования лейкоцитов
2) недостаточное количество лейкоцитов
3) увеличение числа лейкоцитов
4) распад лейкоцитов
6. xerostomia
1) воспаление слизистой оболочки рта
2) сухость конъюнктивы и роговицы глаза
3) сухость рта
4) сухость кожи
7. anaesthesia
1) повышенная чувствительность
2) отсутствие чувствительности
3) пониженная чувствительность
4) паралич группы мышц
8. osteonecrosis
1) омертвление костной ткани
2) омертвление легочной ткани
3) уплотнение костной ткани
4) уплотнение легочной ткани
9. monophobia
1) боязнь высоких мест
2) боязнь одиночества
3) боязнь рака
4) боязнь воды
10. enterolithus
1) венный камень
2) желчно-каменная болезнь
3) носовой камень
4) кишечный камень
11. oligodentia
1) наличие неполного количества пальцев
2) малые размеры пальцев
3) наличие неполного количества зубов
4) большие размеры пальцев
12. lipoma
1) раковая опухоль
2) доброкачественная опухоль из жировой ткани
3) мышечная опухоль
4) образование жировых клеток
13. haematogenus
1) почечного происхождения
2) возникающий в крови
3) кроветворение
4) желудочного происхождения
14. rhinoscopia
1) осмотр слизистой оболочки желудка
|
|
|
2) осмотр полости рта
3) осмотр стенок полости носа
4) истечение секрета из носа
15. tachycardia
1) замедление сердечных сокращений
2) замедленное глотание
3) быстрое заглатывание пищи
4) учащение сердечных сокращений
16. logopaedia
1) исправление прикуса
2) исправление дефектов речи
3) исправление нарушений
опорно-двигательного аппарата
4) расстройство голоса
17. diplegia
1) паралич мышц половины тела
2) двусторонний паралич одноименных частей тела
3) паралич одной конечности
4) недоразвитие органа
18. dermatosis
1) воспаление кожи
2) гнойное заболевание кожи
3) сухость кожи
4) общее название заболеваний кожи
19. hypergia
1) повышенная реактивность организма
2) пониженная реактивность организма
3) повышенная чувствительность
4) нарушение реактивности организма
20. trichalgia
1) головная боль
2) выпадение волос
3) боль при поглаживании волос
4) заболевание волос
21. dacryoadenitis
1) воспаление слезного мешка
2) удаление слезного мешка
3) воспаление слезной железы
4) боль в слезной железе
22. toxicosis
1) наличие ядовитых веществ в крови
2) заболевание, вызванное повышенным
содержанием ядовитых веществ в крови
3) страх отравления
4) наличие ядовитых веществ в моче
23. empyema
1) расширение воздушных пространств в
легких
2) скопление гноя в полости
3) рецидивированное воспаление кожи
4) выворот века
24. leucolysis
1) недостаток лейкоцитов
2) повышенное содержание лейкоцитов в
крови
3) распад лейкоцитов
4) образование лейкоцитов
25. osteonecrosis
1) омертвление костной ткани
2) хроническое заболевание суставов
3) рассасывание костной ткани
4) омертвление хрящевой ткани
26. otorrhoea
1) кровотечение из уха
2) кровотечение из носа
3) истечение слизи из уха
4) истечение секрета из носа
27. hypertensio
1) пониженное артериальное давление
2) нарушение мышечного тонуса
3) повышенное артериальное давление
|
|
|
4) отсутствие мышечного тонуса
28. periarthritis
1) воспаление всех суставов
2) заболевание суставов
3) воспаление мягких тканей, окружающих сустав
4) воспаление хрящевой ткани
29. microglossia
1) малые размеры губ
2) большая голова
3) малые размеры головы
4) малые размеры языка
30. oligodactylia
1) малые размеры пальцев
2) неполное количество пальцев
3) наличие двух пальцев
4) сращение пальцев
31. otoscopia
1) инструментальный осмотр носовой
полости
2) инструментальный осмотр наружного
слухового прохода
3) истечение слизи из уха
4) инструментальный осмотр влагалища
32. angiectasia
1) сужение просвета кровеносных и
лимфатических сосудов
2) опухоль из лимфатических сосудов
3) расширение просвета кровеносных и лимфатических сосудов
4) уплотнение артериальных сосудов
33. thrombophilia
1) воспаление вен с образованием тромба
2) склонность к образованию тромбов
3) венный камень
4) избыток тромбоцитов в крови
34. dystrophia
1) отсутствие питания тканей
2) расстройство мышечного тонуса
3) расстройство питания тканей
4) отсутствие мышечного тонуса
35. arthrosis
1) боль в суставах
2) хроническое заболевание хрящей
3) воспаление сустава
4) хроническое заболевание суставов
36. aplasia
1) состояние безразличия
2) аномалия развития, при которой
отсутствует часть органа или тела
3) невозможность глотания
4) расстройство питания тканей
37. tonsillectomia
1) полное удаление аденоидов
2) полное удаление миндалин
3) частичное удаление миндалин
4) воспаление миндалин
Задание 1.
Переведите иноязычные тексты, используя знание греко-латинских терминоэлементов. Попробуйте определить язык.

Dermatitis is inflammation of the skin. The different kinds usually have in common an allergic reaction to specific allergens. The term may describe eczema, which is also called dermatitis eczema and eczematous dermatitis.

En médecine, l' appendicectomie est un acte chirurgical consistant en l'ablation de l'appendice iléo-cæcal.
Хемолиза (на гръцки: haemo - кръв + λύσις - разрушавам) е разрушаването на еритроцитите и освобождаването на хемоглобин в околната течност (плазма). Причините, които могат да доведат до хемолиза са разнообразни. Така например хемолиза може да се предизвика от автоимунни процеси, висока концентрация на алкохол в плазмата.

La nefritis es una inflamación del riñón. Término del idioma griego nephro- "del riñón" e -itis "inflamación". Es frecuentemente causada por infecciones, toxinas o enfermedad autoinmune.
|
|
|

Остеопороз — системне захворювання скелета, яке характеризується зменшенням маси кістки в одиниці об’єму та порушенням мікроархітектури кісткової тканини, що призводить до підвищення крихкості кісток та високого ризику їх переломів.

La leucémie (du grec leukos, blanc, et haima, sang), ou leucose, est un cancer des cellules de la moelle osseuse. En 1847, Rudolf Virchow, un médecin histologiste allemand, fut l'un des premiers à décrire la leucémie.

La mammografia è un esame del seno umano effettuato tramite una bassa dose (di solito circa 0.7 mSv) di raggi X.
Viene utilizzato come strumento diagnostico per identificare tumori e cisti.

In medicine, hematuria, or haematuria, is the presence of red blood cells (erythrocytes) in the urine.

La néphrite est une inflammation du rein (du grec: nephro-, le rein, et -itis, inflammation). Les deux principales causes de néphrite sont les infections ou les maladies auto-immunes.

La rinoplastica (dal greco antico ρινός, naso) è l'intervento chirurgico che permette di rimodellare il naso.

La hepatomegalia es un aumento patológico del tamaño del hígado.

Die Otosklerose ist eine Erkrankung des Knochens, der das Innenohr umgibt (Labyrinthkapsel).
Гастроентерологията е област от специалността вътрешни болести.
Гастроентерологията се занимава с диагностика, неоперативни терапии (напр. медикаментна терапия) и превенция на болести на стомашно-чревния тракт. Важни гастроентерологични заболявания са например язвите (язва на стомах, на дванадестопрътник), тумори на стомашно-чревния тракт, болестни състояния на черния дроб като цироза на черен дроб и хепатит, заболявания на червата като възпалителните чревни заболявания.

Πνευμονία είναι μια φλεγμονή των πνευμόνων που προκαλείται από βακτήρια, ιούς, μύκητες και άλλουςμικροοργανισμούς.
Задание 2.
1. Наиболее частой причиной моноплегии без уменьшения массы мышц является поражение коры больших полушарий головного мозга.
2. Подскажите, пожалуйста, ваше собственное мнение по поводу применения препарата Durolane для лечения остеоартроза тазо-бедренного сустава, его эффективности, безопасности.
|
|
|
3. В системе гемостаза принимают участие факторы свертывающей, противосвертывающей (антикоагулянтной) и фибринолитической систем крови.
4. В распознавании нефролитиаза помогает анамнез (наличие приступов почечной колики с характерной иррадиацией боли, отхожденне с мочой конкрементов и др.).
5. Вы ответили, что хондрома может теоретически стать злокачественной. А насколько это реально практически?
6. Лапароскопическая холецистэктомия делается через проколы брюшной стенки. Наиболее часто применяемая техника операции предусматривает выполнение четырех проколов, из которых два имеют длину по 5 миллиметров, а другие два – по 10 миллиметров.
7. Гистеропексия применяется при опущении или выпадении матки в сочетании с передней кольпорафией и кольпоперинеорафией. После нее возможны беременность и роды.
8. Одновременно на обеих стопах неврома Мортона встречается очень редко. Эта патология чаще всего проявляется у женщин, что возможно, связано с ношением тесной узкой обуви на высоких каблуках.
9. Основой диагностики гипертиреоза является лабораторный метод. Увеличение в крови концентрации гормонов щитовидной железы (Т4 и Т3) и понижение количества гормона ТТГ определяют как гипертиреоз или тиреотоксикоз. За рубежом гипертиреоз принято называть «болезнью Грейвса».
10. Гепатогенныйпсихоз развивается при таких заболеваниях печени, как болезнь Боткина (инфекционная желтуха), болезнь Васильева-Вейля), хронический гепатит (цирроз печени), острая желтая атрофия печени.
РАЗДЕЛ III
3.1. Латинско-русский словарь
А
achlorhydria, ae f;syn. anaciditas ахлоргидрия, отсутствие соляной кислоты в желудочном соке
achylia, ae f ахилия, отсутствие желудочного сока
actinomycosis, is f актиномикоз, хроническая инфекционная болезнь, вызываемая актиномицетами, характеризующаяся гранулематозным поражением тканей и органов
adenocarcinoma, atis n аденокарцинома, злокачественная опухоль из железистого эпителия
adenocytus, i m аденоцит, железистая клетка передней доли гипофиза
adenoma, atis n аденома, доброкачественная опухоль из железистого эпителия
adenotomia, ae f аденотомия, хирургическая операция удаления аденоидов
adentia, ae f; ( syn. anadentia) адентия, отсутствие нескольких или всех зубов; различают приобретенную (в результате травмы ил заболевания), врожденную и наследственную адентию
adipolisis, is f адиполиз, гидролитическое расщепление жира в процессе пищеварения при участии ферментов
aetiologia, ae f этиология: 1.учение о причинах и условиях возникновения болезней; 2. причина возникновения болезней или патологического состояния
agnathia, ae f агнатия, аномалия развития: отсутствие верхней или нижней челюсти
allergia, ae f аллергия, измененная реактивность организма, повышенная чувствительность организма
allokeratoplastica, ae f;syn. homokeratoplastica аллокератопластика, пластическая операция с применением роговицы, взятой у другого человека
alloplastica, ae f; syn. homopla stica аллопластика, замещение дефектов или исправление деформаций с использованием тканей другого человека
allotransplantatio,onis f; syn. homotransplantatio аллотрансплантация, пересадка органов и тканей от человека к человеку
amnesia, ae f амнезия, потеря памяти, забывчивость
anaciditas, atis, f; см. achlorhydria
anaemia, ae f анемия, малокровие (уменьшение количества эритроцитов или гемоглобина в объемной единице крови)
anaesthesia, ae f анестезия: 1.отсутсвие чувствительности; 2. метод обезболивания при хирургических операциях
anaesthesiologia, ae f анестезиология. Раздел медицины, занимающийся вопросами обезболивания при хирургических операциях
anaesthesiologus, i m анестезиолог, врач-специалист по обезболиванию
anergia, ae f анергия 1.отсутствие реактивности; 2. вялость, инертность
angiectasia, ae f; syn. vasectasia, vasodilatatio ангиэктазия, стойкое расширение просвета кровеносного или лимфатического сосуда
angiitis, itidis f см. vasculitis
angiographia, ae f; syn. vasographia ангиография, рентгенологическое исследование кровеносных или лимфатических сосудов после введения в них контрастного вещества
angioma, atis n ангиома, доброкачественная опухоль, развивающаяся из кровеносных или лимфатических сосудов
angiomatosis, is f; syn. haemangiomatosis ангиоматоз, общее название болезней, характеризующихся избыточным разрастанием кровеносных сосудов
angioneurosis, is f ангионевроз, сосудистая дистония, обусловленная нарушениями функции вегетативной нервной системы
angiopathia, ae f; syn. vasopathia ангиопатия, нарушение тонуса кровеносных сосудов
anthropologia, ae f антропология, наука о происхождении и эволюции человека
anthropometria, ae f антропометрия, совокупность методов и приемов измерения человеческого тела
anuria, ae f анурия, непоступление мочи в мочевой пузырь, отсутствие мочи
anuria, ae f анурия, непоступление мочи в мочевой пузырь
aphthae, arum f афты, изъязвления в полости рта
aplasia, ae f; ( syn. agenesia) аплазия, общее название аномалий развития, при которых отсутствует часть тела, орган или его часть, участок какой-либо ткани
arthropathia, ae f артропатия, общее название поражений суставов дистрофической природы
arthroplastica, ae f артропластика, хирургическая операция восстановления функции сустава путем замещения поврежденных или функционально непригодных его элементов
arthrosis, is f артроз, название болезней суставов, в основе которых лежит дегенерация суставного хряща
asthenia, ae f астения, состояние, характеризующееся общей слабостью организма
atonia, ae f атония, отсутствие тонуса мышц
atrophia, ae f атрофия, уменьшение массы и объема органа или ткани, сопровождающееся ослаблением или прекращением их функции
autoplastica, ae f аутопластика, общее название методов восстановительной хирургии, при которых в качестве пластического материала используют собственные ткани или органы больного
autotransplantatio, onis f аутотрансплантация, пересадка собственных тканей или органов
B
bidactylia, ae f; syn. didactylia бидактилия, аномалия развития: наличие только двух пальцев на руке или на ноге
biologia, ae f биология, наука o строении и функции живых организмов
biopsia, ae f биопсия, прижизненное взятие и исследование кусочка ткани в диагностических целях
blepharitis, itidis f блефарит, воспаление краев век
blepharoplastica, ae f блефаропластика, пластическая хирургическая операция восстановления век или их части
blepharoptosis, is f блефароптоз, опущение верхнего века, обусловленное нарушением функции мышцы, поднимающей его
blepharospasmus, i, m блефароспазм, спазм вековой части круговой мышцы глаза
blepharotomia, ae f блефаротомия, хирургическая операция рассечения века с целью удлинения глазной щели
brachycephalia, ae f брахицефалия, короткоголовость: форма головы человека с относительно большим поперечным диаметром
brachycheilia, ae f брахихейлия, укорочение верхней части губы
brachydactylia, ae f брахидактилия, аномалия развития: укорочение пальцев рук или ног
brachygnathia, ae f брахигнатия, ненормально короткая нижняя челюсть, недоразвитие нижней челюсти
bradycardia, ae f брадикардия, замедление ритма сердечной деятельности
bradykinesia, ae f брадикинезия, замедленность движений
bradyphagia, ae f брадифагия, замедленное глотание
bronchitis, itidis f бронхит, воспаление бронхов
bronchoectasia, ae f бронхоэктазия, расширение ограниченных участков бронхов
bronchogenes, is; bronchogenus, a, um - бронхогенный, исходящий из бронхов, начинающийся в бронхах
bronchostenosis, is f бронхостеноз, сужение просвета бронха
C
calculus salivalis; syn. sialolithus m слюнный камень
carcinogenes, is; carcinogenus, a, um карциногенный, вызывающий развитие раковой опухоли
carcinoma, atis n карцинома, рак, злокачественное новообразование эпителиальной ткани, захватывающие ткани и образующее метастазы
carcinophobia, ae f карцинофобия, навязчивый страх раковой болезни
cardiogramma, atis n кардиограмма, графическое изображение работы сердца
cardiolysis, is f кардиолиз: 1. распад тканей сердца; 2. оперативное освобождение сердца от сокращений при слипчивом перикардите
cardioptosis, is f кардиоптоз, опущение, низкое состояние сердца
cardiorrhexis, is f кардиорексис, разрыв сердца чаще всего острого размягчения миокарда при обширном инфаркте
cardiosclerosis, is f кардиосклероз, склероз сердечной мышцы и сосудов
cardiostenosis, is f кардиостеноз: 1. сужение сердца, особенно артериального конуса; 2. анатомическое сужение отверстия, входа желудка
caries dentium кариес зубов или костоеда зубов, постепенное местное разрушение твердых частей зуба с последующим образованием дефекта в виде полости
caries, ei f кариес, костоеда, распад твердой (костной, зубной. хрящевой) ткани
cephalgia (cephalalgia), ae f; syn. cephalodynia цефалалгия, головная боль
cheilitis, itidis f хейлит, воспаление губ
cheilorragia, ae f хейлоррагия, кровотечение из губы
cheiloschisis, is f; syn. labium leporinum - хейлосхизис, врожденное расщепление верхней губы, заячья губа
cheilosis, is f хейлоз, появление трещин, рагад на губах, в частности в углах рта (гиповитоманоз В2)
chimiotherapia, ae f химиотерапия, лечение химическими средствами, избирательно подавляющими жизнедеятельность микроорганизмов или клеток опухоли
chirurgia, ae f хирургия, отрасль медицины, пользующаяся при лечении болезней главным образом оперативными методами
chirurgus, i m хирург, действующий руками (букв.)
cholaemia, ae f холемия, поступление желчи в кровь
cholecystectomia, ae f холецистэктомия, оперативное удаление желчного пузыря
cholecystitis, itidis f холецистит, воспаление желчного пузыря
cholecystogramma, atis n холецистограмма, рентгенограмма желчного пузыря
cholecystographia, ae f холецистография, рентгенография желчного пузыря
cholecystostomia, ae f холецистостомия, образование фистулы желчного пузыря
cholecystotomia, ae f холецистотомия, оперативное вскрытие желчного пузыря для удаления желчных камней
chondrogenesis, is f хондрогенез, образование хряща
chondroma, atis n хондрома, доброкачественная опухоль из хрящевой ткани
chronometria, ae f хронометрия, измерение времени
chyluria, ae f хилурия, наличие лимфы в моче
cirrhosis, is f цирроз, хроническое разрастание соединительной ткани и постепенное исчезновение паренхимы печени
colopexia, ae f колопексия, прикрепление ободочной кишки к брюшной стенке
colostomia, ae f колостомия, наложение свища на ободочную кишку
colotomia, ae f колотомия, вскрытие ободочной кишки
colposcopia, ae f кольпоскопия, осмотр влагалищных стенок при помощи зеркал
contractura, ae f контрактура, сведение сустава вследствие поражения мягких частей (кожи, мышц, связок, фасций или нервов)
cyanosis, is f цианоз, синюшный оттенок кожи или слизистых оболочек, обусловленный недостаточным насыщением крови кислородом
cysta, ae f 1. пузырь; 2. киста, патологическая полость с жидким или полужидким содержимым
cystitis, itidis f цистит, воспаление мочевого пузыря
cystogramma, atis n цистограмма, рентгенограмма мочевого пузыря после введения контрастного вещества
cystographia, ae f цистография, рентгенологическое исследование мочевого пузыря после введения контрастного вещества
cystolithiasis, is f цистолитиаз, наличие камней в мочевом пузыре
cystoplegia, ae f цистоплегия, паралич мускулатуры мочевого пузыря
cystopyelogramma, atis n цистопиелограмма, рентгеновский снимок почечных лоханок и мочевого пузыря
cystoscopia, ae f цистоскопия, осмотр внутренней поверхности мочевого пузыря при помощи цистоскопа
cystostomia, ae f цистостомия, наложение свища на стенку мочевого пузыря
cystotomia, ae f цистотомия, вскрытие мочевого пузыря
cytologia, ae f цитология, учение о строении, развитии и функциях клетки
D
dactylomegalia, ae f дактиломегалия, чрезмерно большие размеры пальцев рук или ног
dermatomycoses, ium f; syn. d ermatophytiae дерматомикозы, группа микозов, при которых в основном поражаются кожа и ее придатки
dermatophytiae, arum f см. d ermatomycoses
desmurgia, ae f десмургия, раздел хирургии, разрабатывающий технику наложения повязок
diarrhoea, ae f диарея, понос, ненормально частый жидкий стул при усиленной перистальтике
dicephalia, ae f дицефалия, наличие двух голов на разделенной верхней части туловища плода
|
|
|
|
|
Дата добавления: 2015-06-04; Просмотров: 1423; Нарушение авторских прав?; Мы поможем в написании вашей работы!